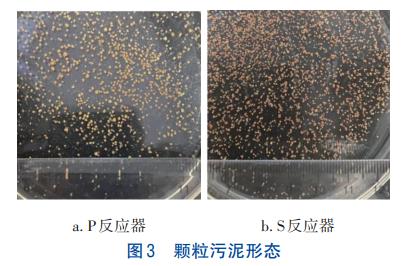
7.jpg 7.jpg

好氧颗粒污泥(AGS)因外形规则、结构紧密且具有较大的沉降速度及优越的污染物降解效果,成为近些年来国内外关注的对象。但目前对AGS的形成及控制体系构建的研究仍不完善,特别是其不稳定易解体的问题限制了该技术的推广应用。AGS一般是在高径比(H/D)超过5的序批式反应器(SBR)中获得。科研人员发现,H/D在15以上时可在1个月内快速颗粒化成功。这是因为较大的H/D延伸了污泥的循环路径,往往会使污泥之间发生更有效的碰撞,理论上促使微生物絮体更易于抱团凝聚,形成结构密实、沉降速率大的颗粒污泥。但较大的H/D存在造价高及控制管理难等问题,因而不适于工程应用,且试验中大多使用的SBR为细长型,其容积一般不大,承载废水的能力相对较低。
由于循环路径短、碰撞频率低,在H/D减小的情况下相对难颗粒化。为解决此问题,最直接的办法是增大曝气量来提高表观气速(SGV)以达到所需的剪切强度,但成本过高。同时,王惠卿等发现,在纯好氧SBR中形成颗粒污泥的时间也较长。关于机械搅拌所起的作用,张小玲等以800r/min的搅拌转速配合鼓风曝气,仅3d便在H/D为3.29的SBR中形成了颗粒;曲新月等在H/D为1.2的SBR中进行325r/min的机械搅拌,定量分析了表观气速和搅拌对剪切强度的贡献率,结果显示后者约高37.48倍;易诚等的研究表明,微生物在搅拌剪切刺激下会分泌胞外聚合物(EPS),最终凝聚成颗粒污泥的初核。这些研究都暗示着机械搅拌的加入或对低H/D中颗粒污泥的形成起到重要作用。但Gao等认为,搅拌的强度难以控制,操作不当还可能导致颗粒破碎。因此,有必要进一步探究机械搅拌对颗粒化影响的关联条件。
活性污泥生物相诊断学技术是指利用光学显微镜实时观察污泥颗粒化过程中的微生物(原、后生动物及部分细菌),通过分析微生物的类别、数量等及时改变和控制活性污泥系统的运行参数。为了对接实际工程的构筑物,并尽可能提升废水的处理量,同时降低曝气量,笔者选用H/D分别为2.5(有效容积为15.70L)和4.4(有效容积为1.76L)的SBR反应器进行试验,采用鼓风机曝气联合水平机械搅拌提供剪切力,研究连续和停歇两种搅拌方式下AGS的基本特性,解析颗粒化过程中较为适宜的搅拌方式、转速及剪切力范围。与此同时,结合生物相诊断及高通量测序等技术,表征颗粒化过程中微生物多样性及种群演替情况,旨在为低高径比反应器中好氧造粒提供参考。
1、材料与方法
1.1 试验装置及运行方式
SBR反应器如图1所示,其由有机玻璃制成。两组反应器中,H1/D1=2.5的SBR简称为P,H2/D2=4.4的SBR简称为S,内径D1=20cm、D2=8cm,高分别为80和70cm,有效高度H1=50cm、H2=35cm,有效容积V1=15.70L、V2=1.76L,容积交换率均为50%。反应器内设有旋浆式搅拌器,其中P的搅拌桨为三层四叶式,桨长12.5cm、高2.5cm。S的搅拌桨为单层,桨长5.5cm、高1.5cm。采用曝气泵曝气,采用玻璃转子流量计调节曝气量。

试验在室温(20~22℃)下进行,每天运行6个周期,每周期240min。其中P反应器为进水20min、出水7min、初始曝气193min、沉淀20min,后期曝气增至203min,同时日间搅拌3个周期,每周期150min,沉淀时间逐渐缩至10min。S反应器为进水3min、出水1min、初始曝气221min、沉淀15min,后期曝气的同时日夜连续搅拌231min,9d后根据运行状况将搅拌缩至120min,沉淀缩至5min。
1.2接种污泥和试验用水
接种污泥取自乌鲁木齐市某在线亚洲精品自拍,精品乱码一区二区三四区视频二沉池的回流污泥,呈黑褐色。试验分三个阶段进行,逐步提高进水浓度,详见表1。

进水为人工配制的番茄酱废水,以新鲜压榨番茄汁作为碳源,采用氯化铵(NH4Cl)和磷酸氢二钠(Na2HPO4)分别提供氮源、磷源。采用无水碳酸钠(Na2CO3)调节pH在7~8之间。合成废水配比参考文献。
1.3 分析项目及方法
污泥沉降比SV5、SV30采用静置沉降法测定,混合液悬浮固体浓度(MLSS)和挥发性悬浮固体浓度(MLVSS)采用重量法测定,沉降速度的测定参照文献,颗粒污泥的均值粒径采用激光粒度分析仪测定,生物相采用光学显微镜观察,颗粒污泥的表面特性采用扫描电子显微镜(SEM)分析。
高通量测序:取适量接种污泥、第28天和第60天的污泥分别置于已灭菌的2mL离心管后立即放入-40℃冰箱中冷藏,然后送至测序公司进一步分析。样本总数为5个,其中J0表示接种污泥,P1、P2及S1、S2分别表示P和S反应器中第28天和第60天的污泥。DNA提取由生工生物工程(上海)股份有限公司完成。提取的具体过程参照E.Z.N.ATMMag-BindSoilDNAKit的基因组DNA提取试剂盒说明书。测序平台为IlluminaMiSeqPE300;电泳条件为2%琼脂糖凝胶;扩增区域为16SrDNA的V3-V4,引物为341F(CCTACGGGNGGCWGCAG)和805R(GACTACHVGGGTATCTAATCC)。
1.4 表观气速及水力剪切力的计算
表观气速的计算:为达到颗粒化所需要的剪切强度,表观气速应大于1.2cm/s。本研究的曝气强度分3种工况,表观气速按式(1)计算。

式中:SGV为表观气速,cm/s;Q为曝气量,cm3/s;A为横截面面积,cm2。
剪切力的计算:本研究中剪切力主要由曝气和机械搅拌提供。两组反应器的表观气速较小且恒定不变,故剪切力的大小可通过搅拌机转速调控,水力剪切力根据式(2)~(5)计算。

式中:τ为水力剪切力,N/m2;μ为水动力黏滞系数,Pa·s(20℃时取1×10-3Pa·s);G为速度梯度,s-1;P为所耗功率,W;V为被搅拌的水体体积,m³;C为阻力系数,本研究取0.2;ρ为水的密度,1000kg/m3;ω为桨板转动的角速度,rad/s;Z为桨板数目(ZP=3,ZS=1);b为桨板高度,bP=0.025m,bS=0.015m;R为桨板外缘至中心轴原点的距离,RP=0.0630m,RS=0.0275m;r为桨板内缘至中心轴原点的距离,rP=0.018m,rS=0;n为转数。
2、结果与分析
2.1 好氧颗粒污泥培养过程及特性
2.1.1 结合生物相的污泥培养过程
活性污泥微生物镜检过程中常能发现钟虫、轮虫等指示性原、后生动物,此类动物的出现对系统调控具有指导意义。图2为光学显微镜下观察到的微生物情况,以P反应器为例。由图2(a)、(f)可知,接种污泥在未进水的情况下闷曝3d后菌胶团比较分散,污泥沉降性很差,且发黑。在40倍镜检下,满视野中出现较多的背腹面呈圆形似表盖的深褐色表壳虫,行动缓慢,肉眼几乎看不见其运动。此为非活性污泥类原生动物,以游离细菌为食,大量出现在活性污泥系统故障时。此时出现表示系统的BOD5污泥负荷率过低,需提高食微比。调整措施:排出部分沉降性能不好的上层污泥后再周期进水。因接种污泥原碳源与本试验不同,需要缓慢适应,故两组反应器先进水至有效高度的50%,7d后逐步提高进水量至预定高度进行驯化培养。

由图2(b)、(g)可知,培养15d的污泥沉降速度变快,40倍下观察到游离菌胶团较少,絮体开始簇拥变大、颜色棕黄,同时可见个别黑色的颗粒污泥凝结核。100倍下显示有大团累枝虫蔟,其属活性污泥类原生动物,常固着于菌胶团上,喜食大肠杆菌、假单胞杆菌等,一般出现在水质澄清的情况下,但大量出现时预示污泥老化。说明此阶段污泥成长较好,逐渐适应了系统,但有老化倾向。
试验进入第Ⅱ阶段后,提高进水COD浓度至1000mg/L左右,出水变浑浊,说明进水浓度升高造成的冲击负荷对系统产生扰动。为减轻波动,起初4d进水高度仅为预定的60%。培养第22天的生物相如图2(c)、(h)所示,观察到异常多的做快速旋转运动的极小微生物——跳侧滴虫,其密集出现预示菌胶团分解,去除COD的效果变差。而作为后生动物之一,轮虫是污水处理效果好、污泥成熟的标志,它的数量在活性污泥系统中相对较少,但作用不容小觑。轮虫以细菌、藻类、原生动物等为食,通过吞噬作用去除胶体、分离细菌,并能利用分泌物持续摄取氮、磷等营养物质。此次用显微镜“之”字型观察,每视野呈现出超过6只匍匐运动的轮虫,大量轮虫的出现说明污泥龄控制过长,需要加强排泥。另外,还观察到每视野中存在1~2条线虫。宏观上,反应器中部分污泥已成粉状,液面有浮渣。调整措施:少量多次循序渐进地进行底部排泥,抑制轮虫等的大量繁殖。
经过连续2d的排泥,反应器活性污泥浓度骤降。为恢复系统活性,加入水平机械搅拌以促进污泥颗粒化。试验进行到第28天时,出现球状和椭球状的好氧颗粒污泥,如图2(d)、(i)所示。100倍下的颗粒污泥较为圆润规则,轮虫、表壳虫等正常出现,且可发现从菌胶团伸出的小口钟虫及丛生的钟虫。钟虫等固着性纤毛虫属活性污泥类原生动物,能促进活性污泥絮凝,且可捕食游离细菌,出现在水质良好、处理水BOD5在20mg/L以下的环境。与此同时,还存在外形酷似钟虫、对污水具有澄清作用的独缩虫。反观试验,沉降速度约为之前的两倍,出水恢复清澈。泥面呈油润光泽胶体状,说明机械搅拌的加入刺激了微生物分泌EPS,在架桥作用下絮体黏附凝聚的同时丝状菌捕捉缠绕细菌,形成颗粒初核,菌体增殖颗粒增大,污泥颗粒化成功。
图2(e)、(j)为第48天的生物相,可见均匀分布的钟虫和轮虫等指示性动物。颗粒化明显,沉降性好、出水清澈,说明反应器运行状况良好。
2.1.2 好氧颗粒污泥形态
第26天和第28天,S和P反应器相继出现颗粒污泥。图3为P、S反应器中AGS的形态。可见,P反应器中颗粒污泥呈形状规则的橙黄色球状,均值粒径为1.25mm。S反应器中颗粒污泥形状仍较为圆润,但均值粒径只有714μm,且颜色多为红棕色。
2.1.3 好氧颗粒污泥微观形貌
图4为P反应器AGS的SEM照片。从图4(a)可知,颗粒污泥为球状构造,结构密实且附着有钟虫,表面褶皱的存在使得其比表面积比活性污泥的大,从而更易与有机物接触,提高对有机物的去除率。此外,颗粒表面分布有孔隙,是溶解氧和营养物质输入及代谢废物输出的通道。研究表明,氨氧化菌(AOB)位于表层100μm内,其代谢产物为亚硝酸盐氧化菌(NOB)的氧化对象,加之颗粒内部300~500μm处孔隙率最大,有利于物质的输入与排出,决定了硝化反应大多发生在颗粒内部200~300μm处,而兼性菌及厌氧菌主要存在于800~900μm处。因此,粒径较小的颗粒硝化菌数量可能少,且形成不了缺氧、厌氧层,导致硝化反硝化作用受限;粒径过大则传质阻力大,细菌不得不进行内源性呼吸,导致活性下降。研究认为,粒径在1.75mm以内时,脱氮效率与粒径大小具有正相关性,而1.6mm左右颗粒污泥的沉降性能、密实程度及表面疏水性更优。本试验中P反应器对有机物的降解能力普遍优于S反应器,再次验证了上述结论。由此可见,过大或过小的颗粒都不适于系统良性发展。

颗粒污泥表面多由球菌和丝状菌组成,也含有少量杆菌和钟虫,如图4(b)所示。研究表明,丝状菌既可以作为菌胶团的骨架,还可以消灭细菌的代谢产物以提高颗粒污泥的结构稳定性。图中的丝状菌交互缠绕包裹着球菌形成密集的网状结构,显示了丝状菌在颗粒污泥形成过程中的框架作用,丝状菌假说值得研究者们进一步探索。
2.1.4 污泥浓度及沉降性的变化
颗粒化过程中污泥浓度的变化如图5所示。

接种污泥的MLSS为5.81g/L,由于闷曝时间的延长,加剧了微生物的内源性呼吸,部分污泥发生自分解,使得沉降性较差的污泥被系统淘汰。P、S反应器的MLSS分别降低至3.86和3.93g/L。随着试验的进行,污泥沉降性逐渐变好,污泥浓度约达到6g/L,S反应器略优于P。运行至第22天,镜检提示两组反应器污泥龄控制过长,污泥老化现象较严重。为确保污泥活性,人工排泥使P和S的MLSS分别降为4.62、3.83g/L,然后通过增加水平搅拌并缩短沉降时间将强剪切力作用下沉降性差的絮体排走,在进水浓度提高的前提下,MLSS得以恢复,最终在第65天分别达到11.13和7.43g/L。
两组反应器污泥容积指数(SVI)的变化见图6。接种污泥的沉降速度为11.42m/h、SVI30为110.15mL/g,沉降性能较差,无机质含量高,MLVSS/MLSS仅为44.48%。运行3d后P和S反应器的SVI30分别上升至139.90、132.32mL/g,MLVSS/MLSS分别为56.82%和57.13%,说明污泥缺乏活性。随着颗粒的形成,污泥沉降性能转好,但在运行的第36天,实验室意外断电,试验被迫中止一天,重新启动试验后,污泥沉降性变差,2d后恢复正常运转。最终P、S反应器中成熟颗粒污泥的沉降速度分别为33.06和21.64m/h,SVI30分别为33.24、33.65mL/g,MLVSS/MLSS高达90.36%和85.71%,表明污泥的活性逐渐增强。Liu等指出,当颗粒污泥的SV30/SV5值超过0.9时,即可视为颗粒化完成。试验终止时,P反应器的SV30/SV5稳定在0.92以上,系统造粒结束;S反应器在0.85左右,说明其颗粒化程度较P反应器低。

2.2 剪切力对颗粒化过程的影响
表观气速及剪切力的变化见表2。可以看出,反应器在工况1阶段主要由曝气产生的表观气速提供剪切力。如前所述,两组反应器各项指标均较好,但较低的表观气速始终难以短时间内达到AGS形成的目的。且在试验开展前,曾尝试在P反应器中以纯好氧方式运行,发现在低曝气量下,污泥未有明显颗粒化趋势;而随着曝气量的提高,逐渐出现颗粒化现象,但同时污泥过度氧化导致其颜色发白,老化解絮。污泥颗粒化需要较高的剪切力,但高溶解氧并非是必然因素。为提供一定的缺氧区以确保反硝化效率,反应器内还需营造较低的溶解氧水平,遂一个月后停止试验。

试验从工况2阶段开始引入水平机械搅拌,以探究低表观气速下搅拌方式及大小对颗粒污泥产生的影响。其中,P反应器为日间周期停歇式搅拌(3次,每次150min),S为日夜周期连续搅拌(6次,每次231min,9d后改为120min)。研究发现,在引入搅拌的第3天,S反应器中首先出现少许300~800μm的橙黄色圆润小颗粒污泥,沉降迅速。2d后在P反应器中也发现了颗粒污泥,粒径在500μm左右,形状有球状、椭球状,出水变得清澈。这说明曝气形成的上升流及搅拌形成的横向流组成交互的二次流场,促使污泥与溶解氧、有机物充分接触,碰撞频率提高的同时营养物质得到循环,微生物满足生长条件,产生了大量新细胞,且在剪切力的刺激下分泌EPS,黏附聚集形成颗粒。
但引入搅拌的第8天,在S反应器中发现,原本较大的颗粒部分变成了薄片状,第9天片状加剧,圆润颗粒大部分消失。这是因为S反应器采用每天6个周期连续搅拌的运行方式,搅拌所激发的水力剪切力较大,率先颗粒化成功,但长时间承受较强的剪切力,使得形成的结构不稳定的大颗粒污泥很快解絮,表面不断解离成小粒径污泥,少数则直接被强力剪切成片状,这与易诚等的研究结果一致。于是,第10天起将每周期的搅拌时间调整为120min,继续运行7d后片状明显减少,小颗粒又作为晶核黏结成大颗粒,但粒度分布不均匀致使500~800μm范围内的颗粒增多,颜色为红棕色。对于颗粒污泥的颜色,推测是因为S反应器的有效高度较低,曝气搅拌时的运动路径较短,被番茄酱这类色度较大的废水沉积所致(此现象在课题组之前的高反应器中未曾发现)。与此同时,P反应器“厚积薄发”,橙黄色颗粒污泥逐渐增大、变多,对废水的处理效能优于S反应器。
工况3阶段,P和S反应器运行正常,两组反应器颗粒污泥的均值粒径都有所增加,在进水浓度提升的情况下仍然能分别保证95%和90%以上的有机物去除率。为进一步探究两组反应器较为适宜的剪切力范围,将P和S反应器的搅拌转速分别加大至220和625r/min,两组反应器中又出现被剪切成片状的现象,降为预定值后,恢复颗粒状态。说明P和S反应器较适宜的剪切力范围分别为0.159~0.186和0.188~0.247N/m2,这与张小玲等获得的数据(0.120~0.184N/m2)接近。
在同为低表观气速条件下,两者出现颗粒污泥的时间相近,但最终P反应器的污泥形状更加圆润、规则,粒径更大,各项指标优于S反应器。说明长时间过高的剪切力并不是低高径比SBR反应器成功颗粒化的要旨,用力不当反而可能适得其反。而采用日间周期停歇搅拌的方式,不仅可以降低能源的损耗,还能够有效减轻强剪切力产生的负担,让污泥也能适时“休整”。
2.3 微生物多样性及种群演替分析
为了探究两种搅拌方式下微生物多样性的变化及群落演替情况,分别对P和S反应器的接种污泥、颗粒化初期、颗粒成熟期的污泥样本进行高通量宏基因组测序,编号依次为J0、P1、P2、S1和S2。经过处理共获得196751条有效序列,各样本有效序列分别为39490、35783、36442、43856和41180条,5个样本的覆盖率均达到100%,说明本次测序结果能充分反映样本的真实情况。
Alpha多样性指数见表3。Ace和Chao指数可表示物种的总数,颗粒化过程中Chao指数的排序为J0<P1<P2,J0<S1≈S2,表明两组反应器较接种污泥时期丰富度都提高了,颗粒形成初期S反应器的丰度高于P反应器,但颗粒成熟后低于P反应器,且基本等于初期总数。Shannon指数用于估计微生物种群的多样性,其值增大,说明群落多样性提高。两组反应器的Shannon指数均大于接种时期,且停歇式搅拌下的P1、P2样品明显高于连续搅拌下的S1、S2。这说明培养初期,S反应器在强剪切力下颗粒化进程加快,但后期长时间强剪切力破坏了微生物最佳的生存环境,导致多样性低于P反应器。Sindall等通过仿真模型也得到了相似结论。

颗粒化过程中细菌在属水平的分布见图7。可知,P和S反应器颗粒化进程中群落组成差异显著,接种污泥时期(J0)不动杆菌属(Acinetobacter)为优势菌群,占37.37%,但当颗粒形成及成熟后其丰度分别降至2.85%、2.78%及0.19%、0.28%。

Acinetobacter作为一种革兰阴性球杆菌,可独立完成异养硝化及反硝化脱氮过程,且有研究表明,其对湿地TN的去除有重要贡献。而在P和S反应器中其均明显降低,这是因为接种污泥原污水基质为乙酸钠,不同于本试验的鲜榨番茄汁。研究发现,以乙酸钠为底物的AGS中以杆菌、球菌为主,而以葡萄糖为底物的多以球菌为主。与此同时,同样兼具硝化反硝化作用的副球菌属(Paracoccus)在颗粒形成后的丰度分别为15.38%、16.39%,较接种污泥占比1.25%显著提高,这与SEM照片显示的成熟AGS多以球菌组成结果一致。
Ferruginibacter、Chryseolinea和Haliscomenobacter隶属于拟杆菌门(Bacteroidetes),被认为具有较好的絮凝能力。Ferruginibacter属有利于有机物的水解,接种时其含量不足1%,在P、S反应器颗粒形成以及成熟后分别增至4.74%、5.72%和5.72%、3.56%,相应的COD去除率逐渐升高。S2的Ferruginibacter属含量较S1降低是因为强剪切力破坏了菌群的微观环境。Xu等认为,Chryseolinea与污泥密度及沉降性能的提高息息相关。本研究中其丰度在接种污泥J0中占1.60%,在成熟颗粒P2、S2中分别为4.82%和5.05%。Haliscomenobacter的富集多被认为会引起污泥膨胀,但Dabert等发现此种菌群也大量存在于高效除磷活性污泥中。该种菌在J0中仅有0.32%,而在P2、S2中分别达到4.45%和2.40%,污泥沉降性能优良,并无膨胀现象,故判断其在本试验中可能对除磷有效果,且P反应器更优。众多研究证明,菌胶团的形成与动胶菌属(Zoogloea)密不可分,它们能够促进EPS的生成。J0中Zoogloea属的丰度仅为1.36%,但在进行搅拌及增加碳源后,微生物增殖,污泥浓度增长,最终其在P2和S2中的丰度分别为5.29%和11.10%,说明搅拌提供的剪切力刺激了该菌分泌EPS。独岛菌属(Dokdonella)和陶厄氏菌属(Thauera)属于变形菌门(Proteobacteria),普遍出现于各废水处理系统中,是去除含氮有机污染物的核心菌群。P2、S2中Dokdonella属的丰度分别为4.06%和2.79%,远高于接种污泥J0(0.22%)。Thauera属丰度在该过程中也有明显增长。
在成熟颗粒样品P2中,一些未正式命名的菌群成为优势种群,如unclassified_Bacteria(6.62%)、Proteobacteria门未分类属unclassified_Rhizobiales(2.74%)、unclassified_Polyangiaceae(2.41%)、绿弯菌门(Chloroflexi)未分类属unclassified_Caldilineaceae(2.59%),这些菌群具有反硝化功能,在接种污泥J0中的含量极少。与此同时,在S2中,具有反硝化能力的优势种群,如unclassified_Betaproteobacteria(8%)、芽殖杆菌属(Gemmobacter,3.18%)、黄杆菌属(Flavobacterium,3.14%)及食酸菌属(Acidovorax,1.70%),说明AGS具有好氧-缺氧-厌氧分层结构,确保了微生物生长繁殖发挥反硝化脱氮功能。此外,硝化螺菌属(Nitrospira)作为典型的硝化功能菌,是最早从污水厂分离出来的,被认为是亚硝酸盐氧化菌(NOB)的优势菌属,也是P和S反应器中的优势菌群。
值得关注的是,浮霉菌门(Planctomycetes)中有一类未能分类的属:unclassified_Planctomycetaceae,该种菌群可以利用亚硝酸盐氧化铵离子生成氮气来获得能量,因此被称作厌氧氨氧化菌。它的占比在两组反应器中都显著升高,且在P2中的占比更大(6%),促进了NH4+-N的去除。有趣的是,还检测出了Saccharibacteria_genera_incertae_sedis属,其在J0中为0.87%,在P2中上升至1.65%,在S2中仅为0.55%。而Wang等启动的短程硝化反硝化系统中此菌群也大量富集,并推测其导致了亚硝态氮的积累。说明P反应器表现出更好的脱氮效果,正是得益于这些细菌的贡献,若能分离富集此类菌株,将有助于实现短程硝化反硝化过程。
优势菌群富集的同时伴随着部分原菌群的消失,这是微生物种群协同竞争作用的结果,不同菌群之间的耦合作用保证了系统对有机物及氮、磷的去除。P反应器较S反应器有更多的脱氮除磷菌,缘于其为微生物营造了舒适的生存环境,故停歇式搅拌培养的AGS具有更好的状态。
3、结论
①可以利用生物相诊断学技术排查系统运行恶化的原因,从而及时调整运行参数,正常运行时可见累枝虫、钟虫、轮虫等优势微生物。
②在鼓风曝气联合水平机械搅拌方式下,S和P反应器在第26天和第28天相继成功颗粒化。S反应器中成熟颗粒污泥为均值粒径714μm的红棕色小颗粒。P反应器中的颗粒呈橙黄色球状,均值粒径为1.25mm,颗粒表面的微生物主要有球菌、丝状菌及少量杆菌和钟虫,表面分布的孔隙为物质进出提供了通道。
③在P反应器中采用日间周期停歇式搅拌较S反应器采用日间周期连续式搅拌的颗粒化结果更好,说明机械搅拌时间及力度需要控制在一定范围。经计算,P和S反应器的适宜剪切力范围分别为0.159~0.186和0.188~0.247N/m2。
④高通量测序结果显示,P反应器中微生物种群多样性及物种丰度高于S反应器。动胶菌属、Ferruginibacter属和Chryseolinea属等是颗粒污泥形成、有机物去除及系统稳定的主要功能菌。系统还存在大量脱氮除磷菌,如兼具硝化反硝化能力的副球菌属,具有反硝化功能的独岛菌属和陶厄氏菌属,具有典型硝化作用的硝化螺菌属以及与除磷有关的Haliscomenobacter属。P反应器中一些未命名的反硝化菌是优势菌群,还存在厌氧氨氧化菌等可能会对亚硝态氮积累做出贡献的菌群。P反应器为微生物提供更舒适的环境是其脱氮除磷效果更优的原因。(来源:新疆农业大学水利与土木工程学院,乌鲁木齐昆仑环保集团有限公司)



